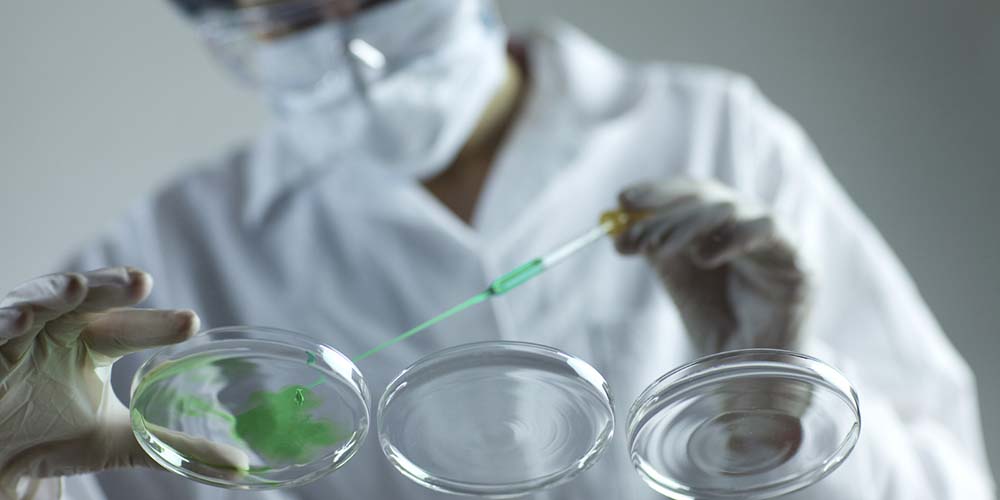
Medicine management software, systems and solutions from DNV GL

Laboratory Medicine Management - Synergi Life
Manage unexpected events and accidents within laboratory medicine
Laboratory medicine management
With the Synergi Life Laboratory Medicine Management software module, you can efficiently manage all unexpected events and accidents within laboratory medicine.
What you get
- Efficient management of unexpected events and accidents
- Report forms
- Categorization
- Actions
- Statistics and reports
With Synergi Life Laboratory Medicine Management software you can
- Manage unexpected events and accidents at hospitals, pharmacies and other health care facilities
- Transfer experience
- Collect feedback
- Analyse causes
- Register frequent pre-analytic incidents for statistical purposes
- Categorize incident reporting
- Identify performed actions
- Close the incident